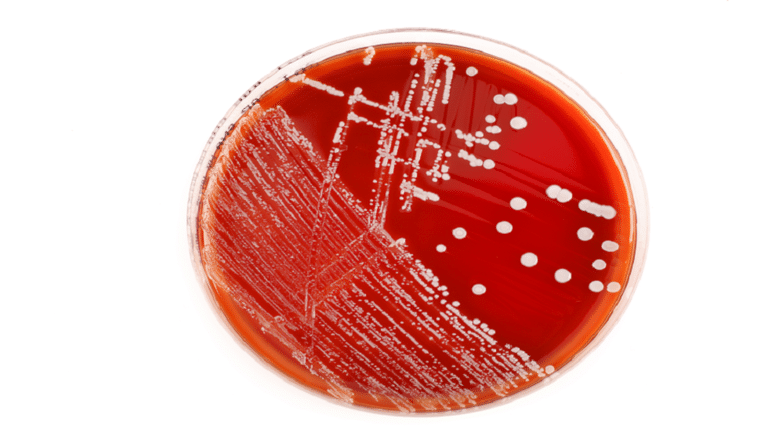

تعد البكتيريا العملاقة الموجودة في مستنقع المنغروف في منطقة البحر الكاريبي هي الأكبر على الإطلاق، ويعتقد العلماء الآن أنهم اكتشفوا كيف نمت إلى هذا الحجم الهائل.
وهذا النوع من البكتيريا، Thiomargarita magnifica، أكبر 5000 مرة من معظم البكتيريا، و50 مرة أكبر من جميع البكتيريا العملاقة الأخرى المعروفة. (يشير اسم Magnifica إلى الكلمة اللاتينية التي تعني "كبير" والكلمة الفرنسية "Magnifique".)
وقال عالم الأحياء البحرية في كاليفورنيا جان ماري فولاند، والمعد الرئيسي للدراسة: "لوضعها في سياقها، سيكون الأمر أشبه بمشاهدة إنسان آخر بطول جبل إفرست".
واكتشف T. magnifica الذي يبلغ طوله سنتيمترا واحدا في إحدى جزر غوادلوب الخضراء المورقة في عام 2009.
وفي وقت الاكتشاف، كان أستاذ علم الأحياء البحرية أوليفييه غروس، يبحث عن البكتيريا التي تستخدم الكبريت لتوليد الطاقة.
ورأى شيئا غريبا جدا، وكانت الخيوط الرفيعة التي تشبه الشعيرية والتي يمكن رؤيتها بالعين المجردة تنجرف فوق الأوراق والأوساخ.
وقال: "عندما رأيتها، اعتقدت أن الأمر غريب. في البداية اعتقدت أنه شيء مثير للفضول، بعض الخيوط البيضاء التي يجب ربطها بشيء ما في الرواسب مثل ورقة الشجر".
وبعد أكثر من عقد من الزمان، قام العديد من الباحثين بإلقاء نظرة على المجاهر لفحص بدائيات النوى الصغيرة الغريبة.
ووخز الكائن الحي غير المعتاد وحفز باستخدام الفلورة والأشعة السينية والمجهر الإلكتروني وتسلسل الجينوم حتى يتمكن العلماء من تأكيد أنها كانت في الواقع بكتيريا عملاقة وحيدة الخلية.
وعند الإبلاغ عن النتائج التي توصلوا إليها في Science، كشف الفريق عن العديد من الآليات الغريبة التي قد تشرح كيف تدفع البكتيريا غير العملية حدود ما هو ممكن نظريا من حيث الحجم.
وعلى عكس الكائنات الحية متعددة الخلايا الأكبر حجما - حقيقيات النوى مثلنا التي تحتوي على عضيات محاطة بغشاء في خلاياها مثل النواة - تنتمي البكتيريا إلى مجموعة من الكائنات الحية تسمى بدائيات النوى، والتي يُعتقد تقليديا أنها "أكياس غير مقسمة من الإنزيمات" مع عدم وجود أغشية داخلية لتقسيم المادة الوراثية.
وقرر الباحثون تسمية هذه العضيات البكتيرية الدقيقة بـ "البيبين" (إشارة إلى البذور الصغيرة الموجودة داخل الفاكهة مثل البطيخ أو الكيوي).
وكتب معدو الدراسة: "نظرا لأنه يفصل المادة الوراثية في عضيات مرتبطة بالغشاء، فإن T. magnifica يتحدى مفهومنا عن الخلية البكتيرية".
ونظرا لأن T. magnifica لديه المزيد من الأغشية الداخلية للعب بها، فيمكنه توزيع آلات البروتين التي تصنع عملة الطاقة للخلايا، ATP (أدينوزين ثلاثي الفوسفات).
ولا تحتوي البكتيريا الأخرى على أغشية داخلية، لذا فإن المكان الوحيد لوضع آلات توليد ATP (سينسيز ATP) هو غلاف الخلية الذي يغلف الكائن الحي بأكمله.
ونظرا لأنه من الصعب نقل هذه الطاقة بعيدا جدا، فإن هذا التقييد يحد من حجم معظم خلايا البكتيريا.
وهناك قيد آخر في معظم البكتيريا هو أنها يجب أن تكون قادرة على مضاعفة حجمها حتى تتمكن من الانقسام إلى نصفين للتكاثر.
وعلى عكس البكتيريا الأخرى، تفصل T. magnifica ببساطة جزءا صغيرا من نفسها لتكوين خلية ابنة، وبالتالي التغلب على هذا القيد.
ويحتوي T. magnifica على جينوم أكبر بكثير من البكتيريا الأخرى - 11788 جينا مقارنة بـ 3935 جينا لمتوسط بدائيات النوى.
وكشف تحليل جيني عن مجموعة من الجينات لأكسدة الكبريت وتثبيت الكربون، ما يشير إلى أن T. magnifica يعتمد على التغذية الكيميائية (يحصد الطاقة من خلال أكسدة المواد الكيميائية).
وخلص الباحثون إلى أنه في حين أن "التحيز المؤكد المتعلق بحجم الفيروس منع اكتشاف فيروسات عملاقة لأكثر من قرن"، فقد تكون هناك بكتيريا عملاقة أخرى "مختبئة على مرأى من الجميع".
المصدر: ساينس ألرت